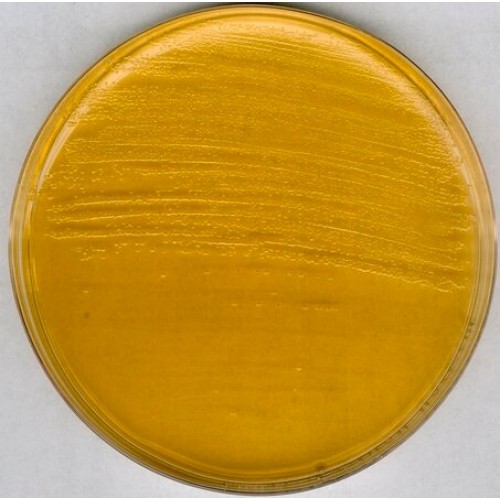
AGAR BHI ( BRAIN HEART INFUSION) GRANULADO MERCK - 500g AGAR BHI ( BRAIN HEART INFUSION) GRANULADO MERCK - 500g

AGAR BHI ( BRAIN HEART INFUSION) GRANULADO MERCK - 500g
Modelo: 1038700500
-
R$982,68
ou até 3x de R$327,56 sem juros
Economize 5% no PIX: R$933,55
ou 3.5% no boleto: R$948,29
Consulte aqui o valor do frete e prazo de entrega
Descrição
BRAIN HEART INFUSION AGAR (BHI) GRANULADO MERCK
RENDIMENTO 52,0g/L MS8014130089
EMBALAGEM 500GR
Typical Composition (g/litre)
Nutrient substrate (brain extract, heart extract and peptones) 27.5; D(+)glucose 2.0; sodium chloride 5.0; di-sodium hydrogen phosphate 2.5; agar-agar 15.0.
Preparation
Suspend 52 g Brain Heart Agar/litre, autoclave (15 min at 121°C). pH: 7.4 ± 0.2 at 25 °C.
The broth is clear and brown, the agar is clear sometimes slightly opalescent and brown.
RENDIMENTO 52,0g/L MS8014130089
EMBALAGEM 500GR
Typical Composition (g/litre)
Nutrient substrate (brain extract, heart extract and peptones) 27.5; D(+)glucose 2.0; sodium chloride 5.0; di-sodium hydrogen phosphate 2.5; agar-agar 15.0.
Preparation
Suspend 52 g Brain Heart Agar/litre, autoclave (15 min at 121°C). pH: 7.4 ± 0.2 at 25 °C.
The broth is clear and brown, the agar is clear sometimes slightly opalescent and brown.
Etiquetas: BHI, Bhai agar, brain heart infusion, agar bhi, 103870, 1038700500, 1.03870.0500